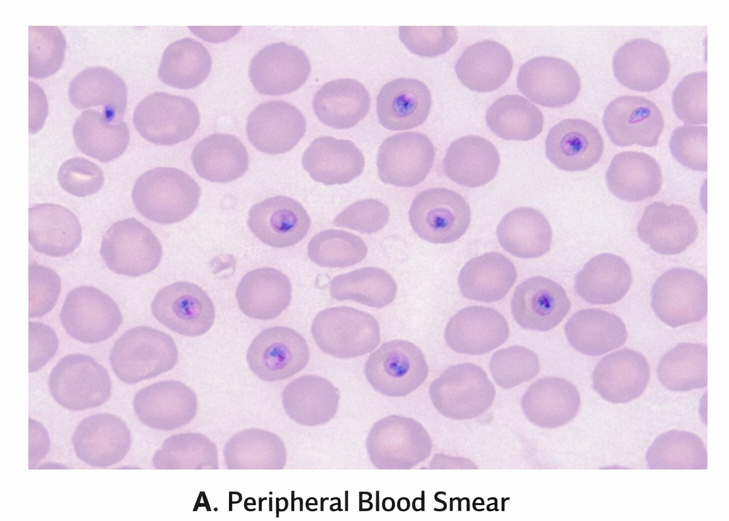

Severe falciparum malaria is a life-threatening infectious disease associated with high morbidity and mortality, particularly in endemic regions. Disease severity is determined by parasite burden, organ dysfunction, host immunity, and timeliness of treatment. Rapid clinical deterioration may occur due to cerebral involvement, severe anemia, metabolic acidosis, renal failure, and multi-organ dysfunction. We report a confirmed case of severe Plasmodium falciparum malaria in a middle-aged male presenting with high-grade fever, altered sensorium, jaundice, and acute kidney injury. This case highlights the clinical presentation, diagnostic challenges, laboratory evaluation, antimalarial management, critical care considerations, and clinical outcomes. The report emphasizes the importance of early recognition, prompt parasitological diagnosis, rapid initiation of parenteral antimalarial therapy, supportive organ-specific management, and structured follow-up to optimize survival and recovery.
Malaria remains a major public health problem in tropical and subtropical regions, with Plasmodium falciparum responsible for the majority of severe and fatal cases. Severe malaria is characterized by complications such as cerebral malaria, severe anemia, acute kidney injury, jaundice, metabolic acidosis, hypoglycemia, respiratory distress, and shock. Delayed diagnosis and inappropriate treatment contribute significantly to adverse outcomes. Early parasitological confirmation, severity stratification, and prompt initiation of evidence-based antimalarial therapy, combined with intensive supportive care, are central to improving survival. This case report describes the clinical presentation, diagnostic workup, management strategy, and outcome of a patient with severe falciparum malaria.
A 48-year-old man presented to the emergency department with a 5-day history of high-grade intermittent fever with chills and rigors, associated with headache, myalgia, nausea, and vomiting. Over the preceding 24 hours, he developed reduced urine output, yellowish discoloration of the eyes, and progressive confusion. The patient had recently returned from a malaria-endemic rural area. There was no history of chronic liver disease, renal disease, diabetes mellitus, or recent drug intake. He had not received malaria chemoprophylaxis. There was no prior history of malaria.
On presentation, the patient was febrile (39.6°C), tachycardic (112/min), hypotensive (BP 90/60 mmHg), and tachypneic (24/min), with oxygen saturation 93% on room air. He was drowsy and disoriented (GCS 12/15). Physical examination revealed pallor, icterus, mild hepatosplenomegaly, and signs of dehydration.

Neurological examination showed no focal deficits. Cardiovascular and respiratory examinations were otherwise unremarkable.
The differential diagnoses included:
• Severe falciparum malaria
• Dengue fever with plasma leakage and hepatic involvement
• Leptospirosis
• Viral hepatitis with sepsis
• Septicemia with multiorgan dysfunction
Peripheral blood smear demonstrated numerous ring forms of Plasmodium falciparum with a high parasitemia index (6%).
Rapid diagnostic test (HRP2 antigen) was positive for P. falciparum. Laboratory investigations revealed severe anemia (Hb 7.2 g/dL), thrombocytopenia (platelets 58,000/µL), elevated serum creatinine (2.6 mg/dL), elevated bilirubin (total bilirubin 4.1 mg/dL), elevated transaminases, metabolic acidosis, and hypoglycemia. Arterial blood gas showed lactic acidosis.

Chest radiograph was normal. Blood cultures were sterile.
Based on clinical features and parasitological confirmation, a diagnosis of severe falciparum malaria with cerebral involvement, acute kidney injury, jaundice, severe anemia, and metabolic acidosis was established.

The patient was admitted to the intensive care unit and managed as per severe malaria treatment guidelines. Immediate parenteral antimalarial therapy with intravenous artesunate was initiated, followed by oral artemisinin-based combination therapy after clinical stabilization. Supportive care included intravenous fluids with careful monitoring, correction of hypoglycemia, blood transfusion for severe anemia, and antipyretics. Empirical broad-spectrum antibiotics were initiated until bacterial sepsis was excluded. Renal function was closely monitored, and intermittent hemodialysis was initiated due to worsening acute kidney injury and oliguria.

Oxygen therapy was provided, and strict input-output monitoring was maintained. Electrolyte abnormalities and metabolic acidosis were corrected.
Over 72 hours, the patient showed clinical improvement with defervescence of fever and improvement in mental status (GCS 15/15). Parasitemia declined significantly on repeat peripheral smear. Renal function gradually improved over 7 days, and dialysis was discontinued. Platelet counts normalized by day 6. The patient was discharged on day 12 in stable condition with normal vital parameters and improving laboratory indices.
At 1-month follow-up, the patient was asymptomatic with normal renal and hepatic function and no neurological sequelae. He was counseled on malaria prevention, vector control measures, and early healthcare seeking behavior in case of recurrent febrile illness.
Severe falciparum malaria is associated with high mortality due to rapid parasite multiplication, microvascular sequestration, and systemic inflammatory responses leading to multiorgan dysfunction. Cerebral malaria, acute kidney injury, metabolic acidosis, hypoglycemia, and severe anemia are key predictors of poor outcome.
Peripheral blood smear and rapid diagnostic tests remain the cornerstone of diagnosis in endemic settings. Intravenous artesunate is the treatment of choice for severe malaria and has been shown to significantly reduce mortality compared with quinine. Comprehensive supportive care, including management of organ dysfunction and correction of metabolic derangements, is critical to improving outcomes. Early referral to intensive care and adherence to standardized treatment protocols substantially improve survival and reduce long-term sequelae.
Severe Plasmodium falciparum malaria is a life-threatening medical emergency that mandates a high index of clinical suspicion, early recognition of severe disease manifestations, prompt parasitological confirmation (by peripheral smear and/or rapid diagnostic tests), immediate initiation of parenteral antimalarial therapy, and intensive, multidisciplinary supportive care. Optimal management requires close hemodynamic monitoring, timely management of complications such as cerebral malaria, acute kidney injury, severe anemia, metabolic acidosis, hypoglycemia, acute respiratory distress syndrome, and shock, along with early escalation to critical care when indicated. This case underscores the critical role of timely diagnosis, rapid therapeutic intervention, vigilant organ-supportive management, and structured post-discharge follow-up in minimizing short-term complications, preventing relapse, and reducing overall morbidity and mortality.
Beyond acute clinical management, sustained malaria control depends on robust preventive strategies, including integrated vector control measures (insecticide-treated bed nets, indoor residual spraying, and environmental management), appropriate chemoprophylaxis and pre-travel counseling for individuals visiting endemic regions, early case detection and treatment to interrupt transmission, and strengthening of public health surveillance and community education. Health system preparedness, clinician awareness in non-endemic settings, and adherence to evidence-based treatment protocols are equally essential to reduce delays in care and improve patient outcomes.
Read more such content on @ Hidoc Dr | Medical Learning App for Doctors
1.
Potential targets for treating the most common type of liver cancer in children have been identified by a collaborative study.
2.
Study identifies new approach to protect the brain during radiation therapy
3.
While most cancer screenings won't prolong lives, there are still good reasons to continue screening.
4.
Chemo-Free Quadruplet Shows Promise as DLBCL's First Therapy.
5.
Radiation therapy for patients with breast cancer
1.
Radiation in Oncology: Advances, Applications, and Accessibility
2.
The Next Generation of Precision: How Multi-Specific Antibodies are Redefining Oncology's Future - A 2025 Review
3.
Cracking Oncology Drug Resistance: New Strategies to Overcome Challenges in Modern Cancer Therapy
4.
Unlocking the Secrets of Neutrophils: Exploring Their Role in Immune Defense
5.
Precision Oncology: Personalized Medicine Shaping the Future of Cancer Care
1.
International Lung Cancer Congress®
2.
Genito-Urinary Oncology Summit 2026
3.
Future NRG Oncology Meeting
4.
ISMB 2026 (Intelligent Systems for Molecular Biology)
5.
Annual International Congress on the Future of Breast Cancer East
1.
Pazopanib Takes Center Stage in Managing Renal Cell Carcinoma - Part II
2.
Recent Data Analysis for First-Line Treatment of ALK+ NSCLC
3.
Navigating the Complexities of Ph Negative ALL - Part XIII
4.
Navigating the Complexities of Ph Negative ALL - Part IV
5.
Revolutionizing Treatment of ALK Rearranged NSCLC with Lorlatinib - Part VIII
© Copyright 2026 Hidoc Dr. Inc.
Terms & Conditions - LLP | Inc. | Privacy Policy - LLP | Inc. | Account Deactivation